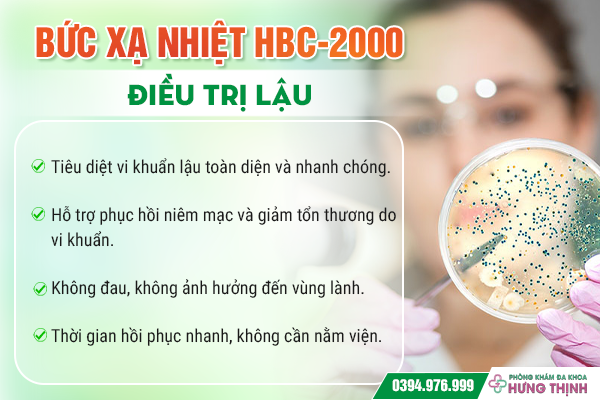

ĐỊA CHỈ KHÁM BỆNH XÃ HỘI UY TÍN TẠI HÀ NỘI - PHÒNG KHÁM ĐA KHOA HƯNG THỊNH
- Tư vấn y khoa: BS. Lê Văn Điển - Hotline: 0394.976.999
Dấu hiệu cảnh báo bệnh xã hội:
Bệnh xã hội là tên gọi chỉ chung của nhóm các bệnh lý lây truyền chủ yếu qua đường tình dục kém an toàn với các bệnh lý phổ biến nhất là lậu, giang mai, sùi mào gà,...
CHUYÊN GIA CẢNH BÁO: Phần lớn các bệnh lý xã hội đều vô cùng nguy hiểm và cần điều trị ngay. Điển hình như lậu, herpes, giang mai làm gia tăng nguy cơ nhiễm HIV; nhiễm trùng HPV gia tăng nguy cơ ung thư cổ tử cung và các bệnh ung thư khác; vi khuẩn lậu phá hủy cơ quan sinh sản dẫn đến vô sinh hiếm muộn…
Vì vậy, chuyên gia khuyến khích người bệnh cần nhanh chóng tìm kiếm địa chỉ uy tín để thăm khám, xét nghiệm kiểm tra bệnh xã hội gấp khi thấy các triệu chứng dưới đây:
- Xuất hiện nốt sùi, mụn nước bất thường tại vùng kín, miệng hoặc hậu môn.
- Ngứa rát, sưng tấy vùng sinh dục, tiết dịch bất thường.
- Tiểu buốt, tiểu rắt, tiểu ra mủ hoặc máu.
- Đau rát khi quan hệ tình dục.
- Cơ thể suy nhược, nổi hạch, sốt kéo dài không rõ nguyên nhân.

[Tôi cần tư vấn về triệu chứng của bệnh xã hội]
Địa chỉ khám bệnh xã hội uy tín tại Hà Nội - Phòng khám Đa khoa Hưng Thịnh
Hiện nay, tại Hà Nội có rất nhiều cơ sở y tế chuyên điều trị các bệnh xã hội. Tuy nhiên, không phải địa chỉ nào cũng đảm bảo được độ uy tín và chất lượng dịch vụ. Phòng khám Đa khoa Hưng Thịnh tại 380 Xã Đàn - Đống Đa - Hà Nội là một trong những cơ sở y tế được đông đảo bệnh nhân tin tưởng lựa chọn nhờ các ưu điểm vượt trội:
Đội ngũ bác sĩ giỏi, giàu kinh nghiệm
Phòng khám Hưng Thịnh quy tụ đội ngũ bác sĩ chuyên khoa nhiều năm kinh nghiệm, từng làm việc tại các bệnh viện lớn như Bạch Mai, Việt Đức... Đặc biệt, các bác sĩ luôn tận tâm với bệnh nhân, tư vấn chi tiết và đưa ra phác đồ điều trị phù hợp nhất.
▶️ Bác sĩ. CKII. Lê Văn Điển: Là 1 trong những bác sĩ ngoại khoa giỏi với hơn 30 năm kinh nghiệm, tham gia phẫu thuật thành công nhiều ca bệnh khó. Ngoài chuyên môn, các bác sĩ còn rất tận tâm, giàu lòng nhân ái và quan tâm đến từng bệnh nhân; mang đến sự hài lòng, tin tưởng cho mỗi bệnh nhân đến với phòng khám.

[Tôi muốn đặt lịch tư vấn với bác sĩ Điển]
▶️ Bác sĩ. CKII. Nguyễn Lương Xu: Từng là Giám đốc Bệnh viện Đa khoa tỉnh Hà Tĩnh. Thực hiện các xét nghiệm quan trọng, phối hợp với bác sĩ chuyên khoa để chẩn đoán. Không chỉ tích cực trong việc khám và điều trị tốt nhất cho các bệnh nhân, bác sĩ còn đóng góp nhiều công trình nghiên cứu quan trọng cho nền y học Việt Nam.
.png)
[Tôi muốn đặt lịch tư vấn với bác sĩ Xu]
▶️ Bác sĩ. CKI. Trần Thị Thành: Là chuyên gia Sản phụ khoa với 40 năm kinh nghiệm, từng giảng dạy 15 năm và đào tạo nhiều thế hệ y bác sĩ giỏi. Với chuyên môn sâu rộng và sự tận tâm, bác sĩ trực tiếp thăm khám, điều trị và mỗi ngày tiếp nhận hơn 200 bệnh nhân, mang lại sự tin tưởng và hài lòng cho người bệnh.

[Tôi muốn đặt lịch tư vấn với bác sĩ Thành]
Cơ sở vật chất hiện đại
Bên cạnh đó, Phòng khám Đa khoa Hưng Thịnh luôn chú trọng đầu tư vào trang thiết bị y tế hiện đại nhằm mang lại chất lượng khám chữa bệnh tối ưu cho bệnh nhân như:
➡︎ Phòng khám được đầu tư hệ thống trang thiết bị y tế tiên tiến, đảm bảo quy trình xét nghiệm nhanh chóng, chính xác và hỗ trợ tối đa quá trình điều trị.
➡︎ Phòng khám rộng rãi, thoáng mát, đảm bảo tiện nghi, hiện đại và được xây dựng theo mô hình khép kín, đồng thời đảm bảo vệ sinh sạch sẽ theo đúng tiêu chuẩn ngành y tế.
➡︎ Môi trường khám chữa bệnh chuyên nghiệp, thân thiện và gần gũi
➡︎ Phòng khám có nhiều dịch vụ hiện đại giúp việc khám bệnh trở nên đơn giản và nhanh chóng, tiết kiệm thời gian như: khám ngoài giờ hành chính và các ngày lễ ngày nghỉ, dịch vụ đặt lịch khám trước.
➡︎ Chi phí luôn được niêm yết rõ ràng, tư vấn cụ thể trước khi người bệnh bước vào điều trị, giúp người bệnh có thể lựa chọn phương án tốt nhất phù hợp với khả năng tài chính.
.jpg)
Phương pháp điều trị tiên tiến
- Sùi mào gà: Phòng khám Đa khoa Hưng Thịnh là địa chỉ uy tín sử dụng phương pháp ALA-PDT điều trị sùi mào gà ở nam và nữ giới, Với công nghệ mới nhất, Phòng khám đa khoa Hưng Thịnh cam kết điều trị dứt điểm sùi mào gà mà không bị mọc lại.

[Chi phí phương pháp có đắt không?]
✅ Loại bỏ mụn sùi: ALA-PDT phá hủy có chọn lọc các mô tổn thương, giúp loại bỏ mụn sùi ở mọi vị trí, kể cả những khu vực khó tiếp cận, mà không ảnh hưởng đến mô lành xung quanh.
✅ Ức chế virus HPV: Phương pháp này kích hoạt phân tử nhạy sáng trong tế bào bệnh, tạo ra phản ứng oxi hóa mạnh giúp phá hủy cấu trúc virus, làm suy yếu và dần loại bỏ chúng khỏi cơ thể, giảm nguy cơ tái phát.
✅ Tái tạo và phục hồi niêm mạc: Không chỉ tiêu diệt mụn sùi, ALA-PDT còn kích thích quá trình tái tạo tế bào, tăng cường hệ miễn dịch, bảo vệ mô lành và cải thiện tính thẩm mỹ sau điều trị.
- Bệnh lậu: Tại Phòng khám Hưng Thịnh, bệnh nhân mắc bệnh lậu có thể được điều trị bằng liệu pháp bức xạ nhiệt HBC-2000 kết hợp Đông y. Phương pháp này sử dụng năng lượng bức xạ siêu dẫn kết hợp thuốc chuyên khoa để tiêu diệt vi khuẩn lậu, đồng thời giúp phục hồi niêm mạc bị tổn thương. Điều trị bằng HBC-2000 mang lại hiệu quả cao, không đau đớn, không ảnh hưởng đến khu vực lành tính và rút ngắn thời gian hồi phục, giúp người bệnh nhanh chóng lấy lại sức khỏe.
.png)
[Chi phí phương pháp có đắt không?]
- Mụn rộp sinh dục: Điều trị bằng phương pháp điện dung sóng ngắn 2D - 2001 kết hợp liệu pháp tăng cường miễn dịch. Đây hiện được đánh giá là phương pháp tiên tiến, hiện đại, được áp dụng phổ biến trong y học dùng để điều trị bệnh mụn rộp sinh dục. Phương pháp lợi dụng cơ chế hoạt động của sóng ngắn để phá vỡ cấu trúc của ổ virus trong các nốt mụn rộp, nhằm ức chế và ngăn chặn sự lây lan của virus HSV gây ra mụn rộp sinh dục
.png)
Phương pháp nổi bật với những ưu điểm chữa trị như:
✅ Thời gian điều trị nhanh chóng, xác định chính xác vùng điều trị và ổ bệnh.
✅ Tăng cường hiệu quả sử dụng thuốc, nâng cao khả năng miễn dịch ở người bệnh.
✅ Phòng tránh bệnh tái phát.
Dịch vụ khám chữa bệnh chuyên nghiệp
Ngoài ra, Phòng khám Đa Khoa Hưng Thịnh mang đến dịch vụ khám chữa bệnh linh hoạt với khám ngoài giờ và mô hình khám kín đáo, giúp bạn có thể điều trị trong điều kiện thoải mái nhất mà không lo lắng về thời gian. Bảo mật thông tin bệnh nhân 100%, kết quả xét nghiệm trả ngay trong ngày. Người bệnh có thể sử dụng dịch vụ đặt lịch hẹn khám trước qua hotline 0394.976.999 hoặc Nhấp vào đây!
- Thời gian làm việc linh hoạt: 8h - 20h tất cả các ngày trong tuần, kể cả ngày lễ.
- Bảo mật thông tin: Phòng khám cam kết bảo mật tuyệt đối thông tin bệnh nhân.
- Chi phí công khai, minh bạch: Bảng giá được niêm yết rõ ràng, không phát sinh chi phí ẩn.

>> ĐẶT LỊCH THĂM KHÁM NGAY HÔM NAY <<
Chi phí khám chữa bệnh công khai
Tại Phòng khám Hưng Thịnh, chi phí khám chữa bệnh hợp lý, được niêm yết công khai minh bạch. Tư vấn cụ thể cho bệnh nhân trước khi tiến hành điều trị. Bên cạnh đó, phòng khám còn triển khai rất nhiều chương trình khuyến mãi ưu đãi. Nhằm giúp cho người bệnh có cơ hội tiếp cận với dịch vụ y tế chất lượng cao với mức chi phí hợp lý.
▪︎ Giảm 30% chi phí tiểu phẫu
▪︎ Giảm 30% chi phí trị liệu
(1).png)
.png)
Đừng chủ quan với bệnh xã hội - Hãy thăm khám sớm để bảo vệ sức khỏe
Bệnh xã hội nếu không được điều trị kịp thời có thể gây ảnh hưởng nghiêm trọng đến sức khỏe sinh sản, thậm chí là tính mạng. Vì vậy, hãy chủ động kiểm tra sức khỏe ngay khi có dấu hiệu bất thường.
Liên hệ ngay Phòng khám Đa khoa Hưng Thịnh qua hotline: 0394.976.999 để được tư vấn miễn phí và đặt lịch khám nhanh chóng!
Địa chỉ: Số 380 Xã Đàn - Đống Đa - Hà Nội
Thời gian làm việc: 8h - 20h hàng ngày (kể cả ngày lễ, chủ nhật)
Hotline tư vấn miễn phí: 0394.976.999
Hãy để Phòng khám Đa khoa Hưng Thịnh đồng hành cùng bạn trong việc bảo vệ sức khỏe!
Phòng khám đa khoa Hưng Thịnh địa chỉ: Số 380 Xã Đàn - Đống Đa - Hà Nội
- Đặt lịch hẹn qua số điện thoại: 0394.976.999 để được đăng ký khám sớm không mất công chờ đợi.
- Thời gian khám chữa: 8h - 20h hàng ngày (kể cả ngày nghỉ, ngày lễ Tết).
- Thời gian tư vấn: 24/24 hàng ngày (kể cả ngày nghỉ, ngày lễ Tết).
- Chi Phí Chữa Sùi Mào Gà Phụ Thuộc Vào Những Yếu Tố Nào?
- Phát Hiện Sùi Mào Gà Ở Đầu Dương Vật – Làm Gì Để Ngăn Biến Chứng Nguy Hiểm?
- Tìm Hiểu Chi Phí Đốt Sùi Mào Gà Tại Hà Nội – Lựa Chọn Địa Chỉ Uy Tín, Giá Minh Bạch
- Tìm Hiểu Về Phương Pháp Đốt Sùi Mào Gà Phổ Biến Hiện Nay – Đâu Là Giải Pháp Hiệu Quả, An Toàn, Ít Tái Phát?
- Hướng Dẫn Quy Trình Đốt Mụn Sùi Mào Gà, Mụn Dương Vật Đúng Chuẩn Y Khoa - Lựa Chọn Địa Chỉ Thực Hiện An Toàn – Kín Đáo – Uy Tín




